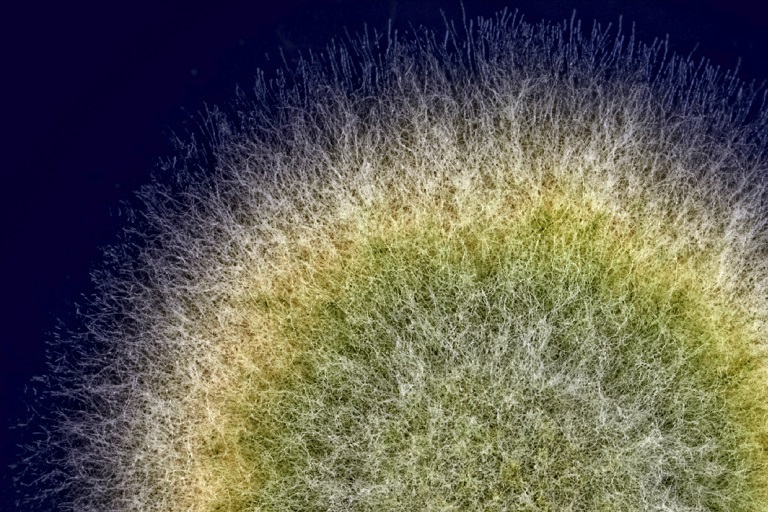
真菌毒素 Mycotoxins

有害物
搜索 >>
污染物
食品污染是指在食品中存在可導致疾病的有害化學物質和微生物。在食品檢測中,污染物通常包括化學污染及微生物污染等。
化學污染物在食品中的存在通常具有持久性,存在於制造過程中的多個加工時期。他們對消費者的影響一般在長期低水平接觸多年後才可顯現出來,可導致癌症、中毒和代謝問題。
最普遍的化學污染物類型
農用化學品:在農業和畜牧業中,使用化學物質去消除害蟲和疾病,提高產量,或降低成本。其中包括各類農藥,畜牧業和水產養殖業中使用的獸藥,熏蒸劑和植物生長調節劑使用。
環境污染物:來自空氣中的(多環芳烴 - PAH),水中的(金屬,溶劑),土壤中的(金屬,硝酸鹽和亞硝酸鹽)。
常見污染物:如戴奧辛及多氯聯苯(PCB)等。
來自包裝材料的污染物:雙酚A,金屬,溶劑和增塑劑。
加工過程中的污染物:來自設備,銅和其他金屬,潤滑油,清潔劑等。
自然產生的污染物:通常被認為是微生物或霉菌生成 - 真菌毒素,植物血凝素,鯖魚毒素等。
不應被添加到食物中的材料:為降低食物材料成本而添加的,如三聚氰胺、皮革水解物,未申報的添加劑,違規彩色染料,蘇丹紅等。
歐陸實污染物的存在。 經由複雜的殘留測試,我們可幫助您的原材料、半成品和最終產品相關的不合規風險降至最低。驗室網絡提供最完整的檢驗方法來檢測食品中的有害物質。